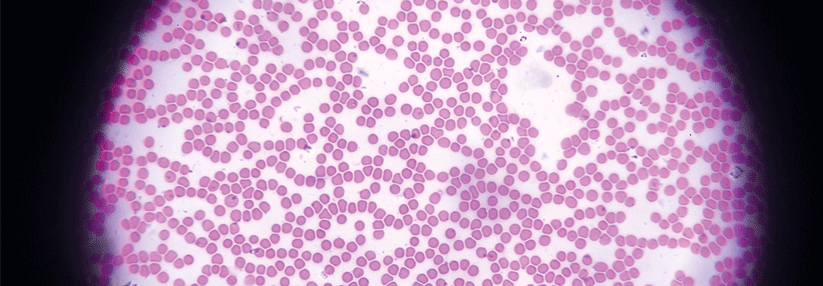

Testosteronspiegel beeinflusst Konsumverhalten
 Männer und Autos: Ein altbewährtes Klischee, das nun bestätigt wurde.
© fotolia/Alexander Lupin
Männer und Autos: Ein altbewährtes Klischee, das nun bestätigt wurde.
© fotolia/Alexander Lupin
Wissenschaftler aus den USA wiesen jetzt erstmals einen kausalen Zusammenhang zwischen dem Interesse an Luxusprodukten und dem Testosteronlevel nach. An ihrer Studie nahmen 243 Männer zwischen 18 und 55 Jahren mit gleichem sozioökonomischem Hintergrund teil.
125 von ihnen bekam ein Gel mit 100 mg des Sexualhormons appliziert, die übrigen ein Placebo. Anschließend präsentierten man ihnen fünf Markenprodukt-Paare gleicher Qualität, die sich in ihrem Ansehen unterschieden (z.B. Calvin Klein – hoher Sozialstatus vs. Levi’s – niedriger Sozialstatus). Probanden mit Testosteron-Überschuss bevorzugten jene Marken, die als die größeren Statussymbole galten.
Für einen zweiten Test erfanden die Studienautoren drei verschiedene Werbetexte für jeweils ein Produkt, die auf unterschiedliche Eigenschaften – Sozialstatus, Power und Qualität – zielten. So wurde z.B. ein Füller von Mont Blanc als „internationales Symbol der Einflussreichen“, als „mächtiger als ein Schwert“ bezeichnet oder ihm u.a. eine gute Haltbarkeit zugeschrieben.
Prestige und Status sind die Zauberwörter
Mit diesen Aussagen konfrontiert, reagierten die Männer ähnlich wie im ersten Test. Diejenigen mit hohem Testosteronlevel bewerteten ein Produkt positiver, sobald der Werbeslogan mehr Prestige oder eine Statusverbesserung suggerierte. Das Versprechen einer gesteigerten Leistung oder die bessere Qualität ließ die Herren dagegen unbeeindruckt.
Quelle: Nave G et al. Nat Commun 2018; 9: 2433